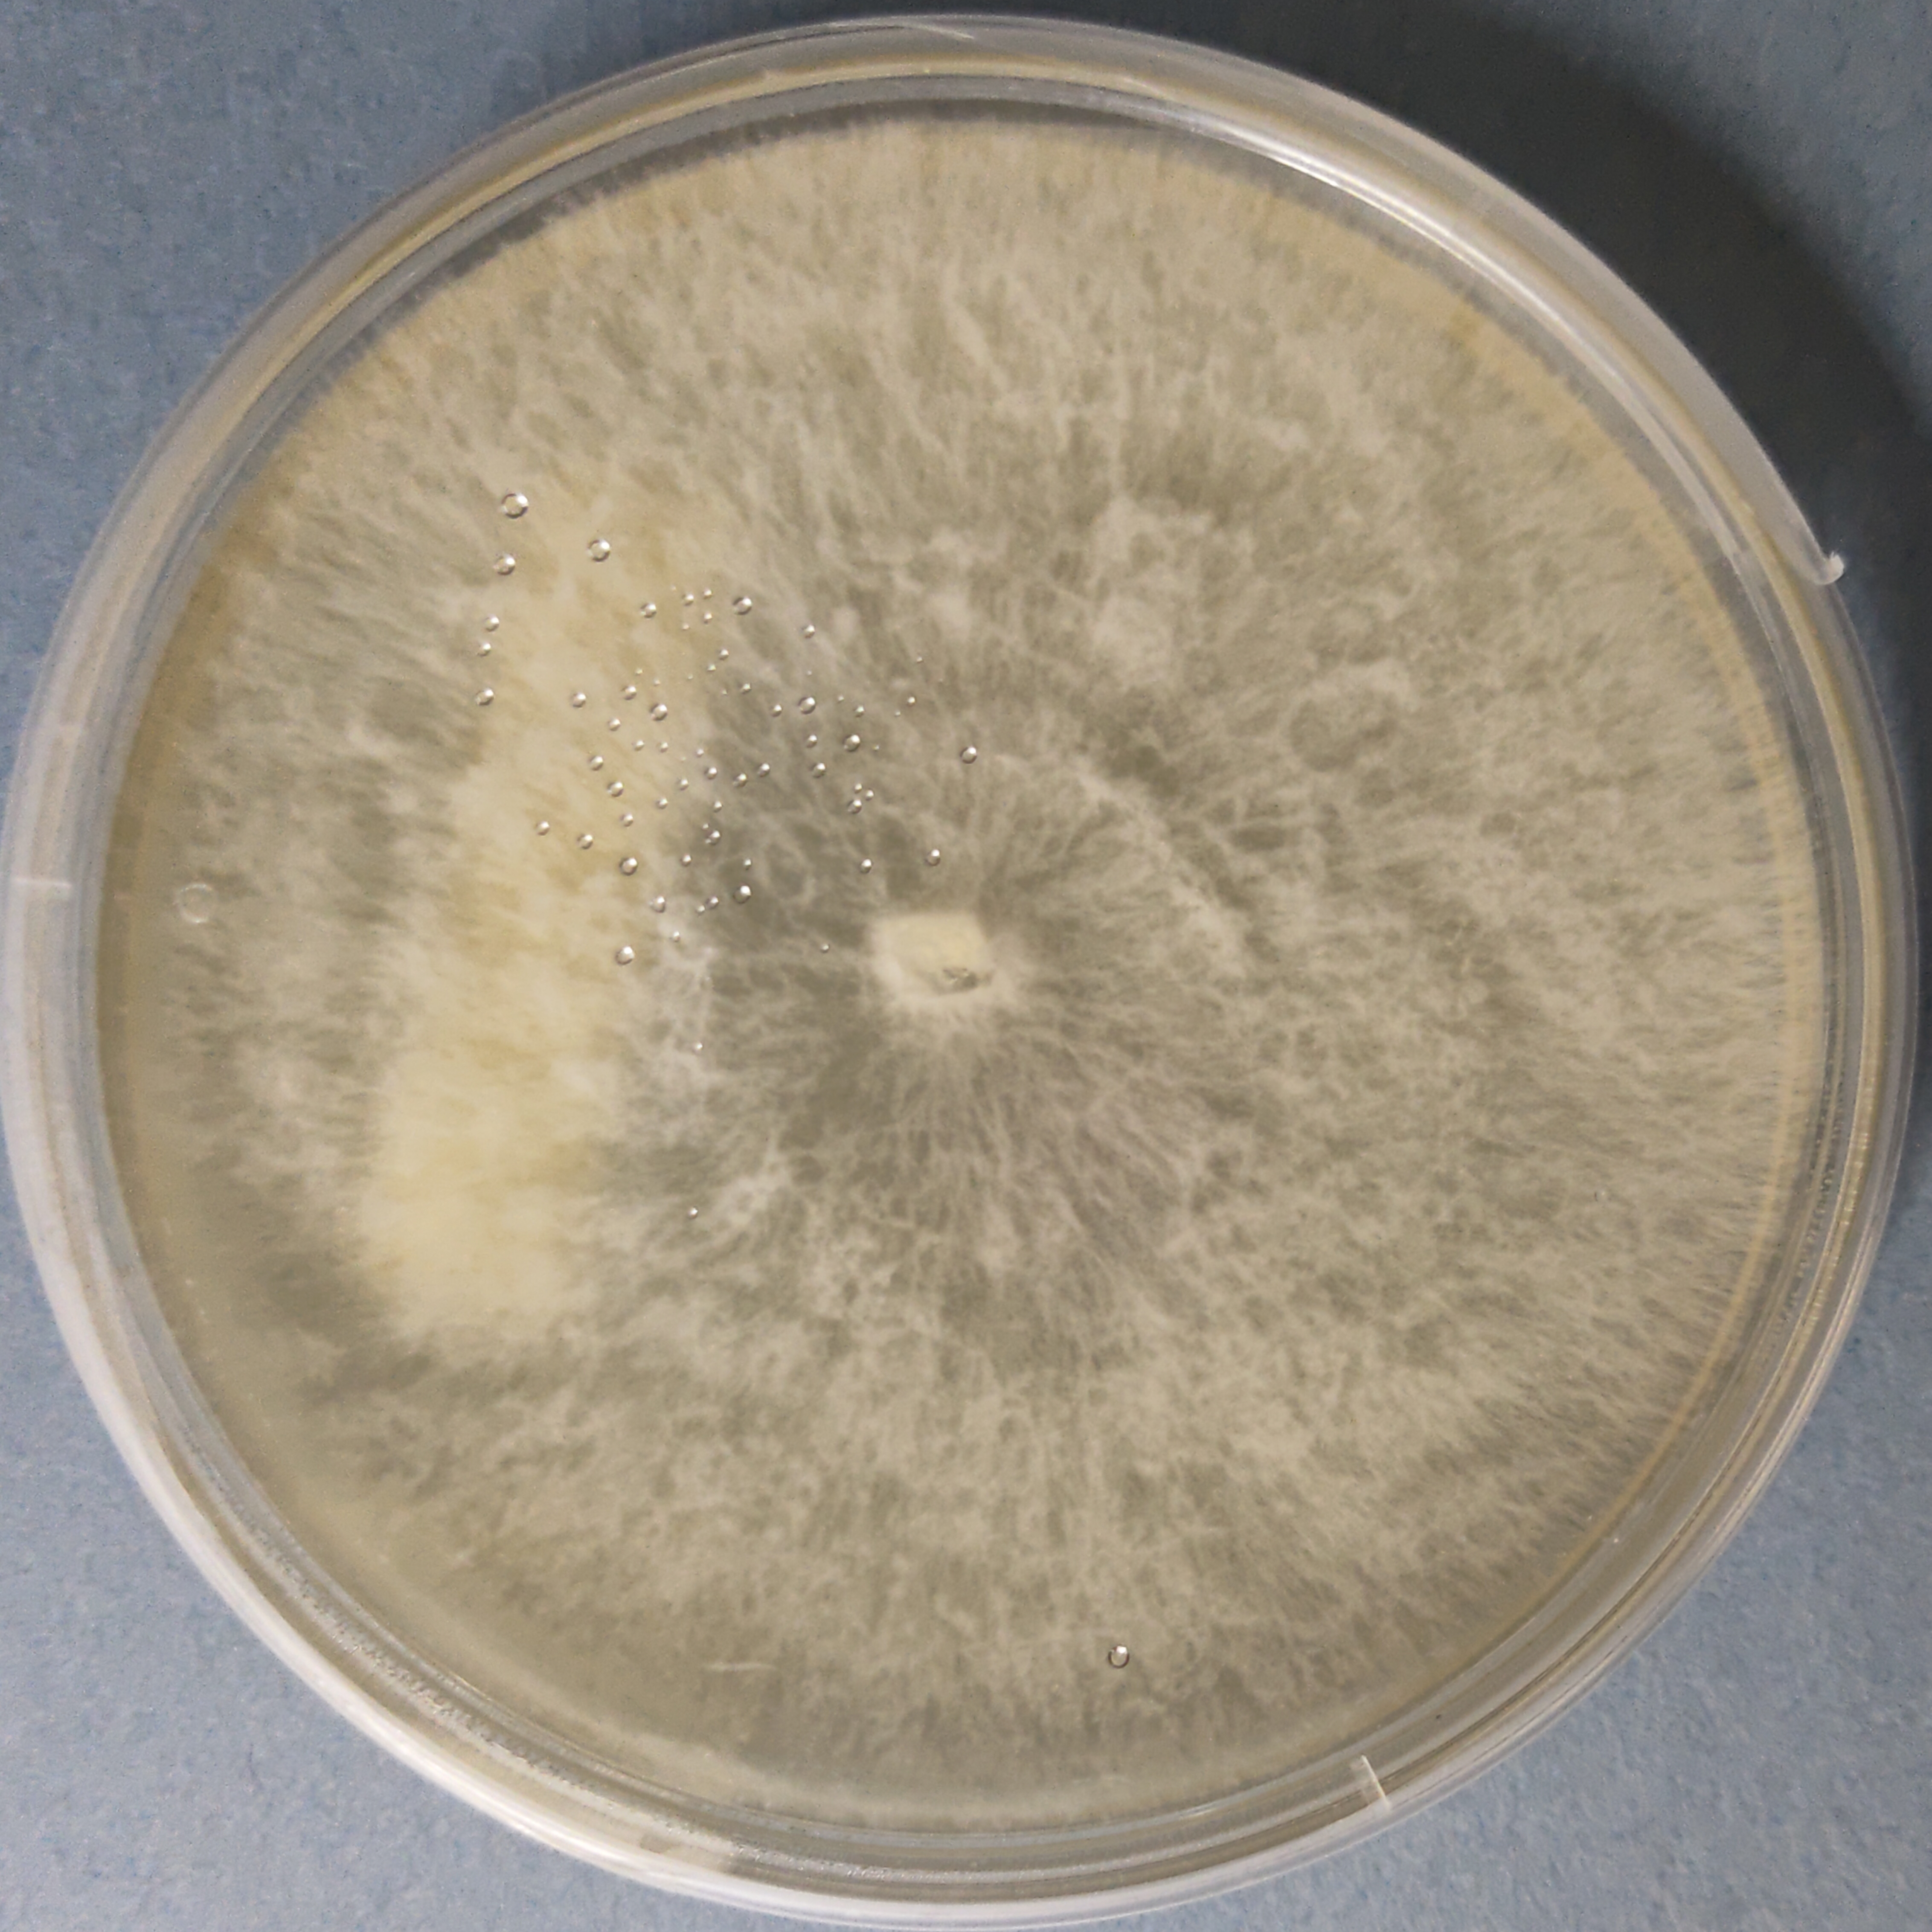
Blue Oyster mushroom culture (Pleurotus columbinus)

Agaricus augustus Culture Plate (Prince mushroom)
Agaricus bisporus Button Mushroom Culture Plate
Agaricus brunnescens Champignon mushroom Culture Plate
Agaricus subrufescens Almond mushroom Culture
Agripie™ MycoLoop – Agar Disc Tool
Agripie™ MycoScalpel – Agar Sectioning Tool
Black Morel Culture Plate (Morchella importuna)
Black Pearl Oyster mushroom Culture (Pleurotus ostreatus)
Black Poplar Mushroom Culture (Cyclocybe aegerita)
Blue Oyster mushroom culture (Pleurotus columbinus)
Ceriporus squamosus Dryad’s Saddle culture
MUHSROOM CULTURE BANK PURE CULTURE - INDUSTRIAL FUNGUS PURE CULTURE - SPECIALTY MUSHROOMS All Products
Cordyceps Capsules Keeda Jadi Mushroom Capsule
Support your health naturally with Cordyceps militaris (Keeda Jadi) capsules – a powerful Ayurvedic supplement known for boosting immunity, energy,
Select options
This product has multiple variants. The options may be chosen on the product page